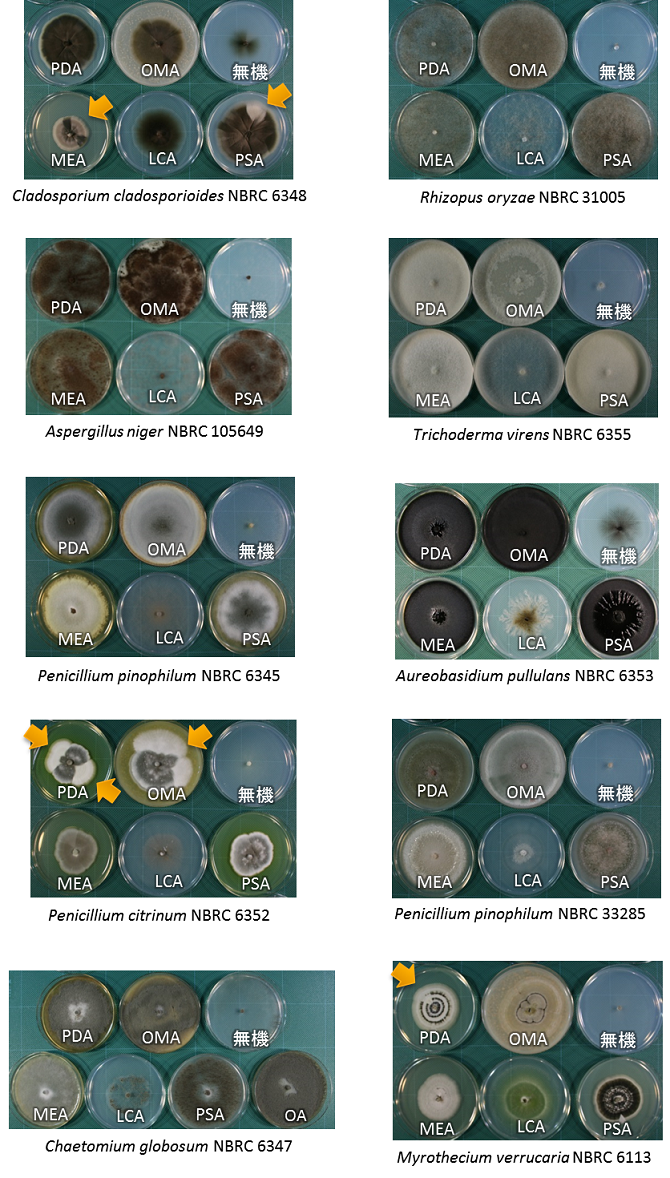
写真1:培養20日目の各培地の様子

かび抵抗性試験で指定される糸状菌株の胞子形成量
NBRCには、糸状菌株が胞子を形成しないという問い合わせがよく寄せられます。そこで、日本工業規格(JIS)Z2911:2010 かび抵抗性試験に規定されるうち、よく利用される糸状菌株について、培地の違いによる胞子(主に無性胞子、Chaetomium属のみ子嚢胞子)形成量を比較しました。
実験方法
供試菌株
JIS検定菌のうち、分譲実績が多い10株および好ちょう性(好乾性)菌の2株。比較対象として、薬局方指定の1株を用いた。
使用培地
本JIS規格で指定される培地は、検定対象と検定に用いる糸状菌株の組み合わせにより異なる。また、NBRCが各菌株に対して推奨している培地もJIS規格とは必ずしも一致しない。そこで、これらのすべての培地を対象に胞子生産性の比較を行った(表2:培地の略号と組成)。
表1:供試菌株と使用培地
| 区分 | 菌名 | NBRC No. | 使用した培地 |
|---|---|---|---|
| JIS検定菌 | Aspergillus niger | 105649 | PDA, OMA, 無機, MEA, LCA, PSA |
| Aureobasidium pullulans | 6353 | ||
| Cladosporium cladosporioides | 6348 | ||
| Myrothecium verrucaria | 6113 | ||
| Penicillium citrinum | 6352 | ||
| Penicillium pinophilum | 6345 | ||
| Penicillium pinophilum | 33285 | ||
| Rhizopus oryzae | 31005 | ||
| Trichoderma virens | 6355 | ||
| Chaetomium globosum | 6347 | PDA, OMA, 無機, MEA, LCA, PSA, OA | |
| 好ちょう性(好乾性)菌 | Aspergillus penicillioides | 33024 | M40Y, M20Y, DG18 |
| Eurotium tonophilum | 8157 | ||
| 日本薬局方指定株 | Aspergillus brasiliensis | 9455 | PDA, OMA, 無機, MEA, LCA, PSA |
培養・測定方法
- 1.前培養は、NBRCが各菌株に対して指定している培地と温度条件で、20日行う。
- 2.9枚の試験対象培地(径9cmシャーレ)の各中央に、直径8mmの打ち抜き寒天片を乗せることによって植え継ぎ、25℃のインキュベーター内で培養する。
- 3.10,20,30日後に、スルホこはく酸ジオクチルナトリウム5%溶液1mLで胞子を回収し、血球計算盤で溶液中の菌数密度を算出する。各菌株・培養期間ともに反復数は3。
結果
JIS検定菌10株については、無機塩スクロース寒天培地で菌糸の生育が抑制されたが、その他の培地では生育不良となることはなかった(図1)。Chaetomium globosum NBRC 6347 はPSA培地のみ1週間後で子嚢胞子が観察されたが、2週目以降ではOMAの方がより良い収量となった。また、MEAでは菌糸は成長するが、子嚢胞子の形成は30日後になっても認められなかった。Cladosporium cladosporioides NBRC 6348、Penicillium citrinum NBRC 6352、Myrothecium verrucaria NBRC 6113のいくつかの培地で、分生子を形成しなくなってしまうことにより、コロニーの一部が白っぽくなり扇状に広がるセクタが認められた。(写真1)
ペニシリウム属菌株
- 10日目まではLCAでの培養で最も形成量が高いが、20日目になるとPDA, PSA, OMAの方が良い。
- Penicillium citrinum NBRC 6352 はセクタができやすいものの、10日目から胞子形成量が多い。P. pinophilumは20日目になってから盛んに胞子を付け、NBRC 33285はNBRC 6345に比べて胞子形成が悪い。
好ちょう性菌株(図3)
- Eurotium tonophilum NBRC 8157はPDA(浸透圧が普通の培地)で全く生えないが、Aspergillus penicillioides NBRC 33024は抑制ぎみであるとはいえPDAでも生える。
- M20YとDG18に有意な差は認められない。

図1:利用頻度の高い菌株の各培地での総胞子数(×10^4).
培養温度は25℃,3反復の平均値±標準誤差を示す.

(参考)
図2:薬局方に定められるAspergillus brasiliensis NBRC 9455の総胞子量(×10^4).
培養温度は25℃, 3反復の平均値±標準誤差を示す.
写真1:培養20日目の各培地の様子.
矢印部は無性胞子を作らなくなった部分(セクタ)が認められる.

図3:好ちょう性菌株の総胞子量(×10^4).
培養温度は25℃, 3反復の平均値±標準誤差を示す.
表2:使用した培地 (組成は1リットル中)
| 略号 | 培地名 | JIS Z2911の 試験区分 |
組成など | |
|---|---|---|---|---|
| PDA | ポテトデキストロース寒天培地 | 皮革及び皮革製品 計測機器、木竹製品 光学部品・光学機器 |
・市販の既製培地を使用 組成表:NBRC medium No. 856 |
|
| OMA | オートミール・麦芽寒天培地 | プラスチック製品 | オートミール 麦芽エキス 寒天 |
20g 10g 20g |
| 無機 | 無機塩スクロース寒天培地※1 | - | リン酸二水素カリウム リン酸水素二カリウム 硫酸マグネシウム七水和物 硫酸ナトリウム 塩化カリウム 硫酸鉄(II)七水和物 スクロース 寒天 |
0.7g 0.3g 0.5g 2.0g 0.5g 0.01g 30g 20g |
| MEA | 麦芽エキス寒天培地 | 電気製品・電子製品 | 組成表:NBRC medium No.5 | |
| LCA | 三浦 LCA培地 | - | ・胞子形成が良いことで知られる 組成表:NBRC medium No. 952 |
|
| PSA | ポテトスクロース寒天培地 | - | ・一般的な糸状菌用にNBRCが指定していることが多い培地 組成表:No. 1 |
|
| OA | オートミール培地 | - | ・Chaetomium属用に指定する培地 組成表:NBRC medium No.8 |
|
| 好ちょう性菌に用いる培地 | ||||
| M40Y | M40Y寒天培地 | 光学部品・光学機器 ガラス製品 |
麦芽エキス 酵母エキス スクロース 寒天 |
20g 5g 400g 20g |
| M20Y | M20Y寒天培地 | ガラス製品 | 麦芽エキス 酵母エキス スクロース 寒天 |
20g 5g 200g 20g |
| DG18 | ジクロラン・18% グリセロール寒天培地 | - | ・市販の既製培地を使用 組成表:NBRC medium No. 1198 |
|
- ※1:附属書A [A.2.2 c)]では、本培地のスクロースに替えてグルコース30±1g/Lを加えたグルコース添加無機塩寒天培地が指定されています。
今回の結果では、規定等に指定された培地を用いて分生子を作らないということありませんでした。また、PSAの代わりとして市販のPDAを用いた場合でも、その性能はほぼ変わらないことが裏付けられました。但し、L-乾燥アンプルから復元した直後の1代目の菌体は、生育の立ち上がりが遅いことが多いと経験的に言われています。安定的に胞子形成を誘導したい場合は、適切な培養条件での前培養を一度通してからにした方が良いでしょう。
菌株詳細データ及び図譜のダウンロード: 3,805KB
【もっと詳しく】 カビに分生子を作らせやすい培養法
PDFファイルをご覧いただくためには、Adobe Reader(無償)が必要です。Adobe Readerはダウンロードページ![]() よりダウンロードできます。
よりダウンロードできます。
お問い合わせ
-
独立行政法人製品評価技術基盤機構 バイオテクノロジーセンター
生物資源利用促進課
(お問い合わせはできる限りお問い合わせフォームにてお願いします) -
TEL:0438-20-5763
住所:〒292-0818 千葉県木更津市かずさ鎌足2-5-8 地図
お問い合わせフォームへ








